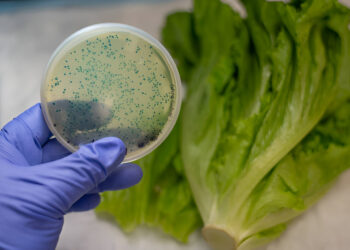
Co-Presence of Antibiotic Resistance Genes and Virulence Genes in Multiple Antibiotic-Resistant Escherichia coli Strains from Leafy Vegetables

Nutritional and Antioxidant Properties of Fermented Kunu Using Lactobacillus plantarum, Lb. fermentum, Bacillus subtilis and Saccharomyces cerevisiae Isolates
Agboola, S. A. 1 Olaniyi O. O. 1 Adeleke, B. S. 1 Akinyele, J. B. 1 Amos-Agboola, O. Y. 1 1Department of Microbiology, Federal University...
Mass Cultivation of Selected Entomopathogenic Microbes
Kelly B. A 1 Atere A. V. 2 Omoseyin O. E. 3 1Department of Microbiology, Adekunle Ajasin University Akungba-Akoko 342111, Nigeria 2Biomedical Science...
Cooking enhances the phenolic content, cholinesterase, and monoamine oxidase inhibitory activities of three varieties of pepper fruits (Capsicum spp.)
Oyeleye I.S;1 Olofin A. T.;2 Oboh G.;3 1Department of Medical Biochemistry, Federal University of Technology, P.M.B. 704, Akure, Ondo State,...
Edible Mushroom Farming: A Viable Protein Alternative and the Need for Public Education in Southwest Nigeria
Olabode O. O. Ph.D 1 1Adeyemi Federal University of Education, Ondo. Download Ebook Cite this article Abstract Protein-energy malnutrition is a...
Co-Presence of Antibiotic Resistance Genes and Virulence Genes in Multiple Antibiotic-Resistant Escherichia coli Strains from Leafy Vegetables
Eniola K.I.T. 1 David O.M. 2 Ajayi P.O. 3 Ajayi O.O. 4 & Adeyemo-Eleyode V.O. 5 1Environmental and Public Health Research Laboratory, Department of Biological...